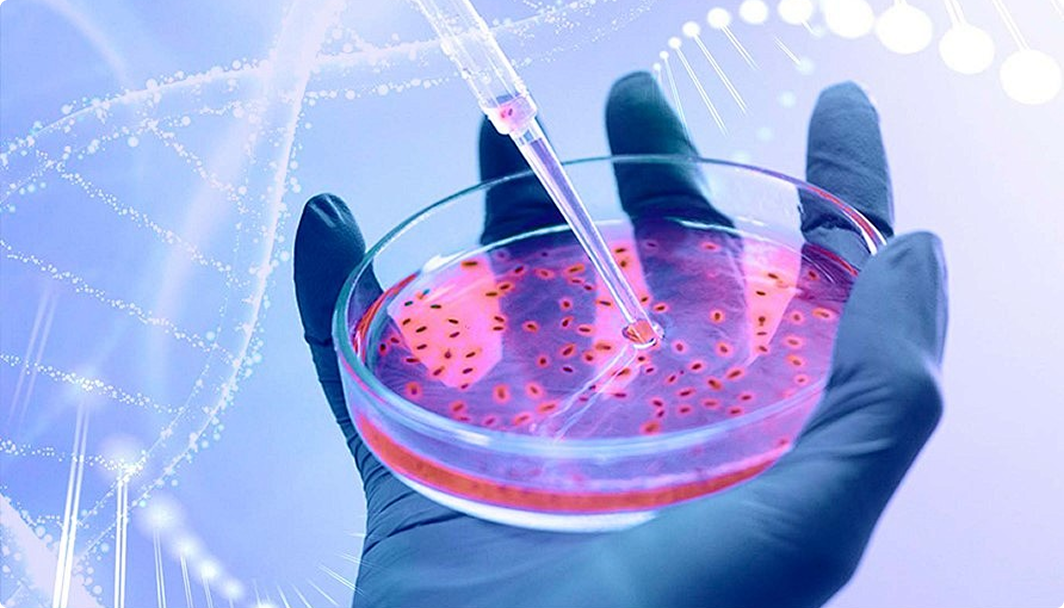

调味品
微生物管理解决方案
针对调味品霉变及发酵致病菌污染风险,提供专业微生物防控方案,运用快检技术精准识 别隐患,助力企业合规降本。同时支持定向开发专用培养基,优化配方,增强检测特异性 ,保障品质
调味品行业-微生物管理解决方案将为您带来什么
专业的微生物管理方案
为调味品食品企业提供全方位的微生物检测与控制服务,确保产品质量安全


全链路检测服务
- 提供水质检测、原料检测、环境检测、成品检测等,保障全链路安全
- 提供菌种鉴定服务,准确定位问题所在
- 提供未知风险分析,提前规避风险


快速检测技术
- 检测时间大大缩短至数小时,减少原料和成品滞留
- 覆盖多种致病菌和霉菌检测,避免漏检

定制化培养基方案
- 根据客户需求定制,可针对需求优化配方,增强检测特异性
- 提供“培养基+检测方法”打包方案


专业支持
- 提供快检和培养所需的菌种、培养基及鉴定试剂
- 协助企业诊断实际问题,制定全链路方案
全链路产品及服务
更多产品


